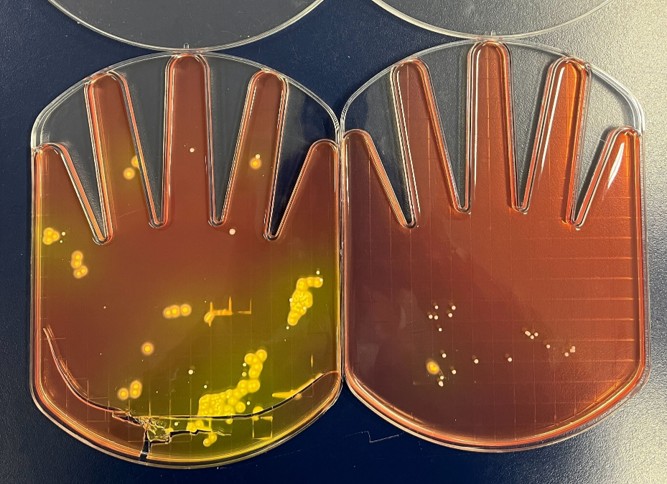
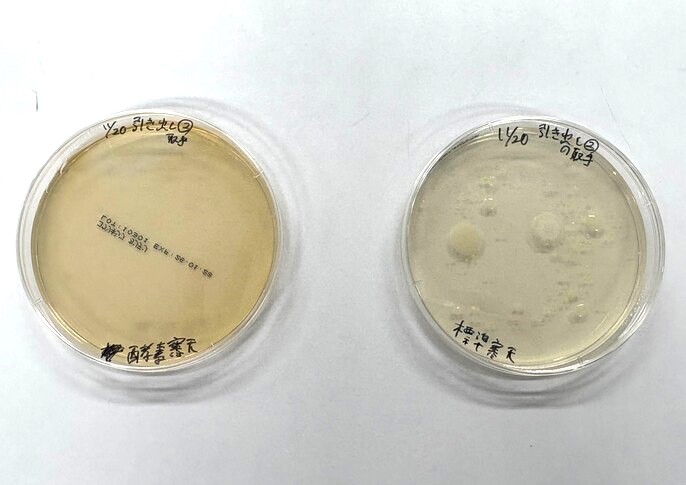
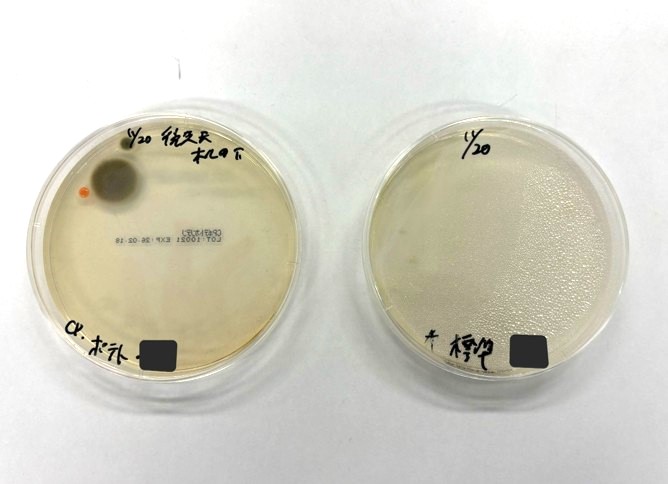

日本工学院八王子専門学校で、食品製造における微生物検査や衛生管理についての講義・実習を行ってきました(2025年11月20日)。応用生物学科1年生の学生の皆さんとの講義と、当社製品の検査用培地を用いた実習の様子をお届けします!
日本工学院八王子専門学校 応用生物学科を詳しく見る
➡ https://www.neec.ac.jp/department/technology-college/biology/
目次
微生物検査に関する講義
前半の講義では、微生物学の基礎知識から始め、食品に潜む微生物が私たちの健康にどのようなリスクをもたらすかを学びました。そして、これらのリスクを未然に防ぐために、消費者庁の定める食品製造に関する各種規格や、現場で実施されている予防策について紹介しました。途中、クイズも交えながら進行し、食品の種類によって規格が異なる点などに学生の皆さんが興味を持ってくださった様子でした。
![]()
【学生さんたちの反応】
- 食品の微生物検査についての知識が深まり、さまざまな食品微生物の分類についても学ぶことができました。
- 食中毒被害の事例から、食品検査の重要性を深く学ぶことができました。特に印象に残っている箇所は生食用カキよりアイスクリームの大腸菌検査基準が厳しいことです。アイスクリームが冷凍庫内で長持ちするのも、厳しい検査ゆえかもしれません。
- 微生物学がどのように品質管理に活かされるのかを知る事ができました。自分自身は、微生物学は食品関係などではあまり扱われないものだと思っていましたが、私達の就職先の候補となる医薬品、化粧品、食品業界の全てに関わっていると知れました。
実習の様子
後半では、前半の講義内容を踏まえて3つの実習を行いました。まず、手洗い実習と手形寒天培地を用いた手のひら検査を行い、製造従事者の衛生状態をどう維持するかについて学びました。次に、実験台や流し、スマートフォンなど、日常的に多くの人が触れる箇所のふき取り検査を行い、製造設備・器具の衛生管理について理解を深めました。最後に、製造環境のモニタリング手法の一例として、各自の好きな場所に平板培地を置いて落下菌検査を行いました。
数日間培養したのち、培地をチェックし、結果の確認・考察をします。本実習では、一般生菌を培養する標準寒天培地に加え、黄色ブドウ球菌や大腸菌・大腸菌群、カビなどの真菌に特化した各種培地を用いて、衛生状態を微生物の数だけでなく種類からも考察していただきました。

①手のひらの衛生確認実習
手洗い前後の手のひらを、手形生培地に押し付けて検査をします。

②ふき取り検査実習
検査したい箇所をスワブキットでふき取り、ふき取り液を培地に塗布します。

③落下菌検査実習
検査したい環境に平板培地を一定時間開放し、培地に自然落下した微生物を捕捉します。
検査結果
①手のひらの衛生検査結果(左:手洗い前 右:手洗い後)
手洗いによって、しっかりと手のひらの菌が減少しています!手洗いの効果が確認できました。
②ふき取り検査結果(左:酵素基質寒天 右:標準寒天)
引き出し取手のふき取り結果です。人の手がよく触れる所なので、菌が付着していたようです。
③落下菌検査結果(左:CP加ポテト 右:標準寒天)
机の下の検査結果です。空気が滞留しやすく埃もたまりやすいせいか、カビが確認されました。
手洗い実習では、製造現場で求められる水準の手洗いが想像以上に入念であることに驚いた学生さんも多かったようです。ふき取り検査や落下菌検査でも、どんな場所が汚れやすいか各々が考えながら実習に取り組む姿が見られ、衛生環境について理解を深めていただく良いきっかけになったのではないでしょうか。
![]()
【学生さんたちの気づき】
- 洗浄により菌数が大幅に減少したことから、手洗いとアルコール消毒が高い効果をもつとわかった。
- 落下菌検査では、空気の流れや環境条件によって付着する菌の数や種類が変化することが確認できました。
- 菌の数が目で見て確認できることがすごい印象に残りました。このようなことをして食品の品質管理を行っているんだろうなとイメージができたので良かったです。
学生の皆さんからの感想
- 製造従事者自身と製造場所・器具の衛生状態を綺麗に保つためにしていることを教えていただき、実際に模した検査をすることができて楽しかったです。
- 見えない微生物でも、正しい手洗いや衛生管理で大きく減らせることを体験を通して理解した。食品衛生において日常的な管理が重要であることを改めて学ぶ良い機会になった。
- 今回の実習では、椅子の拭き取り検査、落下菌検査、手指の衛生評価を行い、環境や人体に存在する微生物の違いについて理解を深めることができました。微生物検査は数値を得るだけでなく、背景要因を考察することが重要であると理解できました。
おわりに
今回参加された学生さんの中には、食品や化粧品の製造業務を志す方が多くいらっしゃいました。本実習をきっかけに、微生物による健康被害の恐ろしさや衛生管理・安全管理の重要性を感じていただけただけでなく、実際に製造の現場でどのように衛生が維持されているのかを具体的に知っていただけたのではないかと思います。今回の学びを糧に、今後皆さんがそれぞれの道でご活躍されますことをお祈りしております!
最後までご覧いただき、ありがとうございました。
教育機関向けの講義・実習への弊社製品使用のご相談や、製品の購入をご検討の際は、ぜひお気軽にお問い合わせください。
食品検査用培地やアレルゲン検査キットなど各製品のサンプルは下記よりお申込みいただけます。
(コラム著者:㈱森永生科学研究所 学術担当 菅村茉莉佳)

